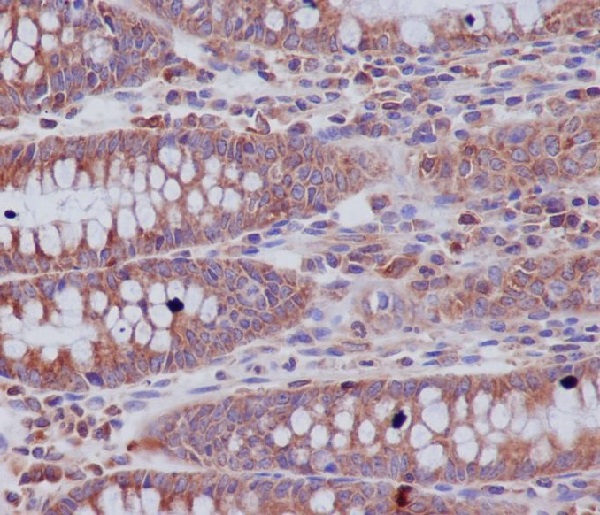

-
分类: 科研抗体货号: P17335别名: H2B 1A; H2B; H2B histone family; H2B2f; H2Ba; H2Bf; HIST2H2BF; histone H2B; histone H2B type 1; Histone H2B type 2-F;;Acetyl-Histone H2B (K20)应用: WB,IHC/IHF,IF,IP/ChIP,FCM反应种属: Human,Mouse,Rat
-
分类: 科研抗体货号: P17317别名: ATG9A; APG9-like 1; Autophagy 9-like 1 protein; Autophagy-related protein 9A; MGD3208; MATG9; APG9 autophagy 9-like 1; APG9L1; Autophagy related 9A;;ATG9A应用: WB,IHC/IHF,IF,IP反应种属: Human,Mouse,Rat
-
分类: 科研抗体货号: P17352别名: Delta type opioid receptor; Delta type opioid receptor DOR1; DOR 1; mDOR; Nbor; Opioid receptor delta 1; OPRD 1;;DOR 1应用: WB;FCM反应种属: Human,Mouse,Rat
-
分类: 科研抗体货号: P17334别名: RARalpha1; NR1B1; RAR-alpha; Retinoic acid receptor alpha; RAR;;Retinoic acid receptor alpha应用: WB;FCM反应种属: Human,Mouse
-
分类: 科研抗体货号: P17316别名: ABC27; ABC50; ABCF1; ATP-binding cassette 50; ATP-binding cassette 50 (TNF-alpha stimulated); TNF-alpha-stimulated ABC protein;;ABCF1应用: WB,IHC/IHF,IF,反应种属: Human,Rat
-
分类: 科研抗体货号: P17351别名: ATP-dependent helicase SMARCA4; BRG1-associated factor 190A; BAF190A; Mitotic growth and transcription activator; Protein BRG-1; Protein brahma homolog 1; SNF2-beta;;SMARCA4应用: WB,IHC/IHF,IF,IP/ChIP反应种属: Human,Mouse,Rat
-
分类: 科研抗体货号: P17333别名: Apoptotic protease Mch4; CASP10; Caspase 10; FLICE2; ICE like apoptotic protease 4; FADD-like ICE2; ;Caspase 10应用: WB,IHC/IHF,IF,IP,FCM反应种属: Human,Mouse
-
分类: 科研抗体货号: P17313别名: QR2; DHQV; DIA6; NMOR2;;NQO2应用: WB;FCM反应种属: Human,Mouse,Rat
-
分类: 科研抗体货号: P17348别名: I 1; I1; Inhibitor 1; IPP1; Ppp1r1a; Protein phosphatase 1 regulatory (inhibitor) subunit 1A;;PPP1R1A应用: WB,IHC/IHF,IF,IP,FCM反应种属: Human,Mouse,Rat
-
分类: 科研抗体货号: P17332别名: Keratin, type I cytoskeletal 13; Krt1-13; Cytokeratin 13; CK13; Keratin 13; KRT13; WSN2;;Cytokeratin 13应用: WB,IHC/IHF,IF,反应种属: Human,Mouse

鄂公网安备42018502007531号
鄂公网安备42018502007531号

